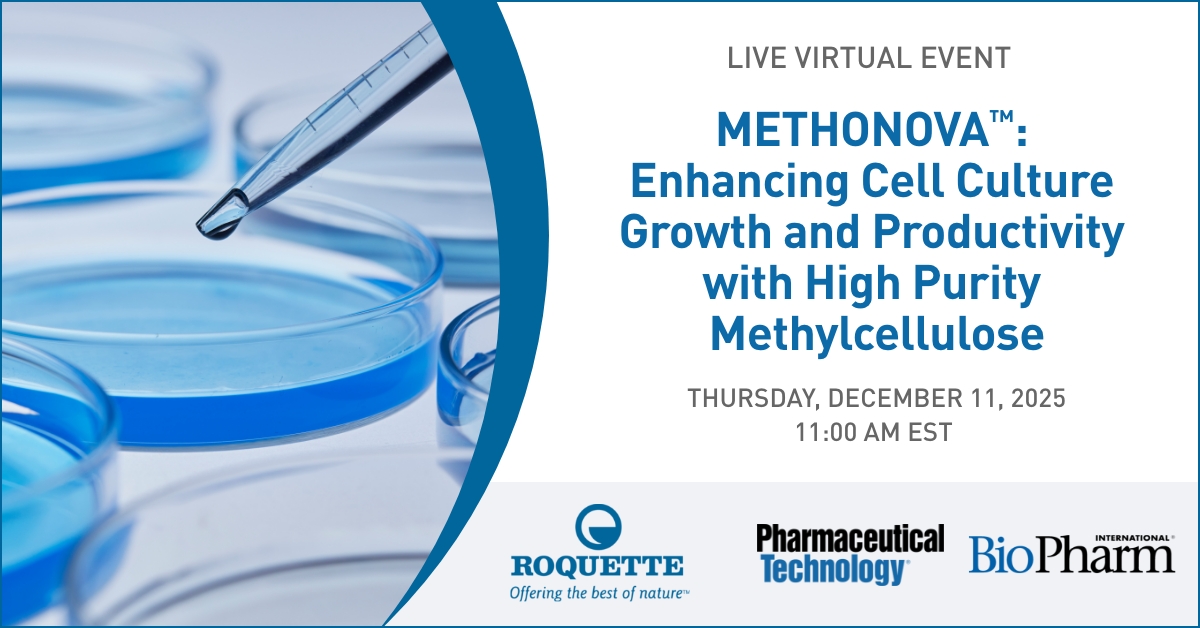
Unlock the potential of high-purity methylcellulose in biotech. Join our upcoming webinar to explore how METHONOVA™ enhances cell culture performance and supports safer cryopreservation.

Register Now: hubs.li/Q03VRWGH0

BioPharm Intl
@biopharmintl
Talking biopharmaceuticals, biotechnology, bioprocessing and related pharma manufacturing.
ID: 263819136
http://www.biopharminternational.com 10-03-2011 20:11:51
6,6K Tweet
3,3K Takipçi
287 Takip Edilen


In this short clip, Sara Underwood, Alturas Analytics, points to the importance of strategic #CRO relationships for PK studies to ensure #regulatory readiness. Watch her full interview from #PharmSci360 here: hubs.li/Q03T7dJ00 American Association of Pharmaceutical Scientists


A report from UK Parliament forebodes a warning to the #pharma industry about the importance of being able to commercialize R&D. Read about it here: hubs.li/Q03TmjzW0


#ConstructiveBio & RxCelerate aim to advance programmable biology for next-gen biologics targeting liver fibrosis. How can #noncanonicalaminoacids transform R&D? #AIforBiotech #SyntheticGenomics #Biologics Read up on their collaboration here: hubs.li/Q03VfGdd0


#ICYMI Catch up on our #PharmSci360 conference recap; digital twins, AI adoption, and critical skills in #biopharma are highlighted. How is your team adapting? #LifeSciences #AIinBiopharma #DigitalTwins American Association of Pharmaceutical Scientists View our recap here: biopharminternational.com/view/ai-adopti…